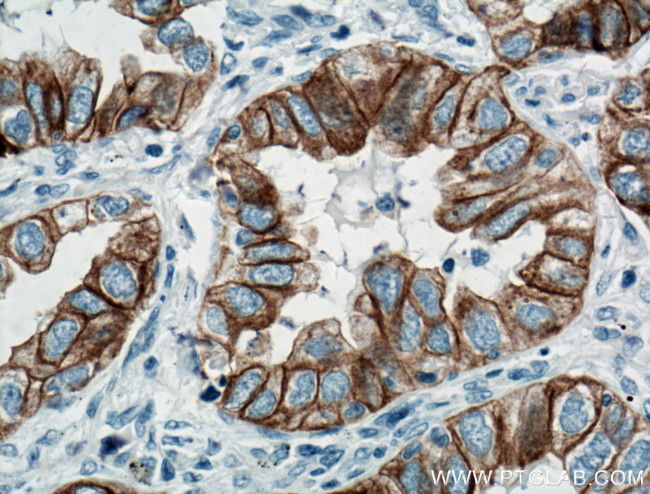
Cytokeratin 7 Antibody in Immunohistochemistry (Paraffin) (IHC (P))
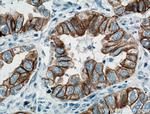
Cytokeratin 7 Antibody in Immunohistochemistry (Paraffin) (IHC (P))

Search
Proteintech
Cytokeratin 7 Monoclonal Antibody (2E1G5)
{{$productOrderCtrl.translations['antibody.pdp.commerceCard.promotion.promotions']}}
{{$productOrderCtrl.translations['antibody.pdp.commerceCard.promotion.viewpromo']}}
{{$productOrderCtrl.translations['antibody.pdp.commerceCard.promotion.promocode']}}: {{promo.promoCode}} {{promo.promoTitle}} {{promo.promoDescription}}. {{$productOrderCtrl.translations['antibody.pdp.commerceCard.promotion.learnmore']}}
产品信息
66483-1-IG
种属反应
宿主/亚型
分类
类型
克隆号
抗原
偶联物
形式
浓度
规格
纯化类型
保存液
内含物
保存条件
运输条件
产品详细信息
This antibody is specifically against KRT7.
Immunogen sequence: MSIHFSSPV FTSRSAAFSG RGAQVRLSSA RPGGLGSSSL YGLGASRPRV AVRSAYGGPV GAGIREVTIN QSLLAPLRLD ADPSLQRVRQ EESEQIKTLN NKFASFIDKV RFLEQQNKLL ETKWTLLQEQ KSAKSSRLPD IFEAQIAGLR GQLEALQVDG GRLEAELRSM QDVVEDFKNK YEDEINRRTA AENEFVVLKK DVDAAYMSKV ELEAKVDALN DEINFLRTLN ETELTELQSQ ISDTSVVLSM DNSRSLDLDG IIAEVKAQYE EMAKCSRAEA EAWYQTKFET LQAQAGKHGD DLRNTRNEIS EMNRAIQRLQ AEIDNIKNQR AKLEAAIAEA EERGELALKD AR (1-351 aa encoded by BC002700)
靶标信息
Cytokeratin 7 blocks interferon-dependent interphase and stimulates DNA synthesis in cells. Involved in the translational regulation of the human papillomavirus type 16 E7 mRNA (HPV16 E7).
仅用于科研。不用于诊断过程。未经明确授权不得转售。
生物信息学
蛋白别名: CK-7; cytokeratin 7; Cytokeratin-7; intermediate filament protein; K7; K7; keratin 7, type II; keratin, 55K type II cytoskeletal; keratin, simple epithelial type I, K7; Keratin, type II cytoskeletal 7; Keratin-7; Sarcolectin; type II mesothelial keratin K7; Type-II keratin Kb7; unnamed protein product
基因别名: CK7; K2C7; K7; KRT7; SCL
UniProt ID: (Human) P08729
Entrez Gene ID: (Human) 3855